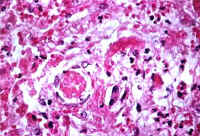

|
Fig. 10-1-1 Vascular amyloidosis; Notice in this picture the greenish material accumulated In the wall of a portal arteriole. The deposition may be concentric or patchy. Sulfated alcian blue stain.
|
li-10-1: Disorders of the hepatic arteries. By Dr. E. Orfei
1-ARTERISCLEROSIS
2-AMYLOIDOSIS
3-ANEURYSMS
4- ARTERIAL-VENOUS FISTULA
5-HEPATIC INFARCTS (Ischemic infarcts; Red Zahn infarcts; Eclampsia;)
6- ARTERITIDES
7-ARTERIAL CHANGES IN HEPATIC TRANSPLANT
1-Arteriosclerosis.
Extra and intrahepatic branches of the hepatic artery may be affected. The reduction of arterial blood flow will not damage significantly the liver if the portal circulation is intact; however, simultaneous occlusion of arterial and portal circulations will result in a massive liver infarct.
2-Amyloidosis.
Vascular amyloidosis causes thickening of the arterial wall in intra-parenchymal
hepatic arteries similar to arteriosclerosis. This type of amyloidosis does not
infiltrate the lobular plates of hepatocytes. It is poorly visible with a conventional H&E stain but it should not be missed. An amyloid stain is required.
 |
Fig. 10-1-1 Vascular amyloidosis; Notice in this picture the greenish material accumulated In the wall of a portal arteriole. The deposition may be concentric or patchy. Sulfated alcian blue stain.
|
Click on picture to enlarge
3-Aneurysms.
They may involve extra and intrahepatic arteries. Extrahepatic aneurysms are more common. They are rare. Sixty per cent are caused by polyarteritis nodosa and are
radiographically detectable. They may rupture and bleed intraperitoneally or into the bile ducts. Very few dissecting aneurysms have been reported.
4-Arterial-venous fistulae.
In intra hepatic fistulae between hepatic artery and portal vein will cause portal hypertension. They may be the result of trauma or inflammation. They are discovered with CT scan, Doppler ultrasound and angiography. Intrahepatic fistulae may close spontaneously. Extrahepatic fistulae tend to expand and should be treated as soon they are discovered.
5-Hepatic infarcts.
The liver has three blood circulatory systems: hepatic artery, portal vein and hepatic veins. Plus, it has a rich collateral arterial circulation. The artery supplies 35% of blood and 50% of oxygen. The liver is capable of surviving on portal blood flow alone.
Because of this arrangement, the formation of infarcts is rare in this organ and requires the concomitant circulatory deficiency of at least tow systems.
Personal example from an autopsy: a 71-year-old lady had had a massive bowel infarct, which required resection of large portion of the small intestine. She had also severe systemic arteriosclerosis. She died 4 years after her bowel resection with a massive ischemic infarct of the while liver caused by thrombosis of the hepatic artery very near its origin and before the branching of the gastric and gastroduodenal arteries, a situation that did not permit the development of a collateral circulation. The acute infarct of the liver occurred because of the existing reduced blood supply from the portal vein since 4 years now complicated by the acute occlusion of the hepatic artery.
The liver forms pale ischemic infarcts and red hemorrhagic infarcts of Zahn. The size of the infarct depends on the size of the occluded vessels.
Pale Ischemic infarcts may result from arterial occlusion, portal vein occlusion or only from low flow, in cases of shock, without any vascular occlusion.
The last occurrence appears to be the cause of the"hemilateral degeneration of the right lobe of the liver" that may cause death of the neonate, mechanically deprived of oxygen during delivery. While the left lobe in the fetus is supplied by the umbilical vein, which is well oxygenated, the right lobe is entirely supplied by the portal vein, which is poorly oxygenated.
Any maneuver, which decreases further the oxygen supply to the fetus, may cause necrosis of the right lobe and may be fatal. This same mechanism, deprivation of oxygen during delivery, may also be the cause of multiple ischemic infarcts which when they heal by scar will result in the so-called congenital hepatic fibrosis.
Arterial infarcts are pale. They have irregular shape and the margins are hyperemic and infiltrated by inflammatory cells. The necrosis in the infarcted area involves hepatocytes, portal fields and hepatic veins. In less severe ischemia the portal fields and periportal hepatocytes may be spared.
The most common causes of ischemic infarctions are polyartertis nodosa, embolization and accidental ligation of hepatic artery. Small infarcts heal by scar.
The red hemorrhagic infarcts of Zahn are due to occlusion of small intrhepatic portal vein branches. The infarcted area is usually peripheral, triangular, with the base toward the glissonian capsule. The sinusoids become distended. There is no ischemic necrosis. The area becomes red, congested, because of back-flow from the hepatic veins and from the artery. Decreased portal vein pressure and increased hepatic vein pressure are the two requisites for the formation of Zahn infarcts. The increased pressure in the hepatic veins seems to be the determinant force. The thrombosis of the small intrahepatic portal vein is probably a consequence and not the cause of the infarct. Indeed a red infarct can be produced also with the total occlusion of an intrahepatic radical of the hepatic veins, a so-called localized Budd- Chiari which causes the highest back-flow pressure in the liver.
Multiple small hemorrhagic infarcts are the characteristic of toxemia of pregnancy consisting of Pre-eclampsia and Eclampsia mostly occurring in late, third trimester of pregnancy.
Pre-eclampsia consists of hypertension, proteinuria and edema. The addition of convulsions characterizes eclampsia. These conditions are systemic with leukocytosis, hemolytic anemia, thrombocytopenia and disseminated intravascular coagulation (DIC). The liver is secondarily involved. Jaundice is rare and mild. Histologically the liver may shows non-specific portal inflammation, periportal canalicular cholestasis, diffuse sinusoidal dilatation, focal ballooning of hepatocytes and presence of eosinophilic bodies. Multiple small hemorrhagic infarcts and necrosis are seen in15-20% of the cases.
The hemorrhagic infarcts are due to fibrin thrombi in small portal veins and in periportal sinusoid. Periportal fibrin thrombi have been observed even in normal pregnancy. (Rolfes DB &Ishak AG: Am. J. Gastroenter.81:1138, 1986) Thrombosis of a hepatic artery caused by DIC will result in ischemic infarcts of the liver. These changes subsidize promptly after delivery but if there is the combination of hemolysis (H), elevated liver enzymes (EL) and low platelets (LP), the fatidic HELLP syndrome there will be 10% infant mortality and 3-4% maternal mortality.
Click on picture to enlarge
|
Fig.10-1-3: Eclampsia. Periportal area with hepatocellular necrosis and fibrin thrombi in the sisusoids. Masson stain.
|
 |
Fig . 10-1-3A: Ecalmpsia Post- mortem liver showing numerous small hemorrhagic infarcts, collapse and atrophy.
|
6-Arteritis: polyarteritis nodosa. necrotizing angitis, Giant-cell arteritis
Hepatic arteries are involved in two thirds of the patients affected by polyarteritis nodosa. There is an increased incidence of polyarteritis nodosa in chronic hepatitis B. Intra-parenchymal arteritides, especially in the portal fields, is usually overlooked because of the rarity of their occurrence and because they are confused with non-specific portal inflammations. Also intra parenchymal veins may be affected by vasculitis. Necrotizing angitis is commonly seen in drug addicts. Giant cell arthritis affects most frequently the cranial vessels but the condition is generalized and it can involve the aorta. The arteries of the liver are very rarely involved.
7-Arterial lesions in hepatic transplant.
These acute vascular complications include thrombosis of hepatic artery and portal vein, and formation of anastomotic aneurysms. These complications are more frequent in children. A slow thrombosis may save the liver. A sudden thrombosis will necrotize the liver and requires re-transplantation. The chronic vascular changes in the liver are similar to those occurring in cardiac and renal transplantation, namely: late transplantation arteriopathy consisting of immunologic damage of the arterial wall with lymphocytic inflammation, intimal thickening, uniform tubular stenosis, fibrinoid necrosis, atheroma formation and ultimate thromboses. (See the chapter on liver transplantation).